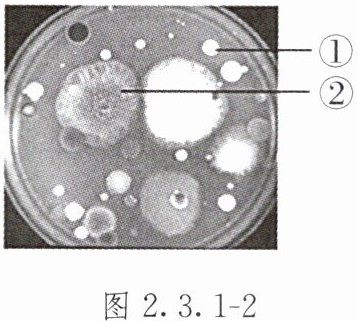

第84页
- 第1页
- 第2页
- 第3页
- 第4页
- 第5页
- 第6页
- 第7页
- 第8页
- 第9页
- 第10页
- 第11页
- 第12页
- 第13页
- 第14页
- 第15页
- 第16页
- 第17页
- 第18页
- 第19页
- 第20页
- 第21页
- 第22页
- 第23页
- 第24页
- 第25页
- 第26页
- 第27页
- 第28页
- 第29页
- 第30页
- 第31页
- 第32页
- 第33页
- 第34页
- 第35页
- 第36页
- 第37页
- 第38页
- 第39页
- 第40页
- 第41页
- 第42页
- 第43页
- 第44页
- 第45页
- 第46页
- 第47页
- 第48页
- 第49页
- 第50页
- 第51页
- 第52页
- 第53页
- 第54页
- 第55页
- 第56页
- 第57页
- 第58页
- 第59页
- 第60页
- 第61页
- 第62页
- 第63页
- 第64页
- 第65页
- 第66页
- 第67页
- 第68页
- 第69页
- 第70页
- 第71页
- 第72页
- 第73页
- 第74页
- 第75页
- 第76页
- 第77页
- 第78页
- 第79页
- 第80页
- 第81页
- 第82页
- 第83页
- 第84页
- 第85页
- 第86页
- 第87页
- 第88页
- 第89页
- 第90页
- 第91页
- 第92页
- 第93页
1. 小明在检测教室内的细菌和真菌时,制作的培养基上出现了几种不同类型的菌落,则下列是细菌的菌落的是( )。
A.菌落大,呈絮状
B.菌落小,呈蛛网状
C.菌落小,表面光滑黏稠
D.菌落大,呈绒毛状
A.菌落大,呈絮状
B.菌落小,呈蛛网状
C.菌落小,表面光滑黏稠
D.菌落大,呈绒毛状
答案:
C
2. 图 2.3.1 - 1 是面包发霉后形成的不同颜色的斑点,下列说法错误的是( )。

A.斑点是霉菌的菌落
B.一个斑点是由一个霉菌大量繁殖后形成的
C.一个斑点就是一个霉菌
D.面包上不同颜色的斑点是由不同的霉菌形成的

A.斑点是霉菌的菌落
B.一个斑点是由一个霉菌大量繁殖后形成的
C.一个斑点就是一个霉菌
D.面包上不同颜色的斑点是由不同的霉菌形成的
答案:
C
3. 下列不能作为培养基原料的是( )。
A.土壤浸出液
B.琼脂
C.细沙
D.牛肉汁
A.土壤浸出液
B.琼脂
C.细沙
D.牛肉汁
答案:
C
4. 棉棒、培养皿和培养基在使用前都要经过( )。
A.在阳光下晒干
B.高温灭菌
C.用水清洗干净
D.用热水烫过
A.在阳光下晒干
B.高温灭菌
C.用水清洗干净
D.用热水烫过
答案:
B
5. 用无菌棉棒擦拭桌面,再在培养基上轻轻涂抹,这是细菌和真菌培养方法的哪一步骤?( )
A.配制培养基
B.高温灭菌
C.在恒温箱中培养
D.接种
A.配制培养基
B.高温灭菌
C.在恒温箱中培养
D.接种
答案:
D
6. 下列对细菌和真菌培养方法的叙述,错误的是( )。
A.要先配制含有营养物质的培养基
B.配制好的培养基不用进行高温灭菌就可以直接接种
C.没接种前不能随意打开培养基的盖子
D.接种后要将培养基放在恒温的培养箱或温暖的地方进行培养
A.要先配制含有营养物质的培养基
B.配制好的培养基不用进行高温灭菌就可以直接接种
C.没接种前不能随意打开培养基的盖子
D.接种后要将培养基放在恒温的培养箱或温暖的地方进行培养
答案:
B
7. 在“检测不同环境中的细菌和真菌”探究活动中,选用两套培养皿的目的是( )。
A.采集同一环境中的样品,在不同环境中培养
B.分别采集两种环境中的样品
C.设置对照组,且实验组和对照组要在同一环境中培养
D.设置对照组,且实验组和对照组分别在两种环境中培养
A.采集同一环境中的样品,在不同环境中培养
B.分别采集两种环境中的样品
C.设置对照组,且实验组和对照组要在同一环境中培养
D.设置对照组,且实验组和对照组分别在两种环境中培养
答案:
C
8. 图 2.3.1 - 2 是培养空气中细菌和真菌的结果,下列叙述错误的是( )。

A.图中①是由一个细菌繁殖形成的集合体
B.图中培养基可以为细菌或真菌的繁殖提供无机盐
C.接种时将培养皿盖打开,在空气中暴露 5 ~ 10 分钟即可
D.真菌菌落通常较大,有的呈现红、褐、绿、黑等不同的颜色
A.图中①是由一个细菌繁殖形成的集合体
B.图中培养基可以为细菌或真菌的繁殖提供无机盐
C.接种时将培养皿盖打开,在空气中暴露 5 ~ 10 分钟即可
D.真菌菌落通常较大,有的呈现红、褐、绿、黑等不同的颜色
答案:
B
查看更多完整答案,请扫码查看


